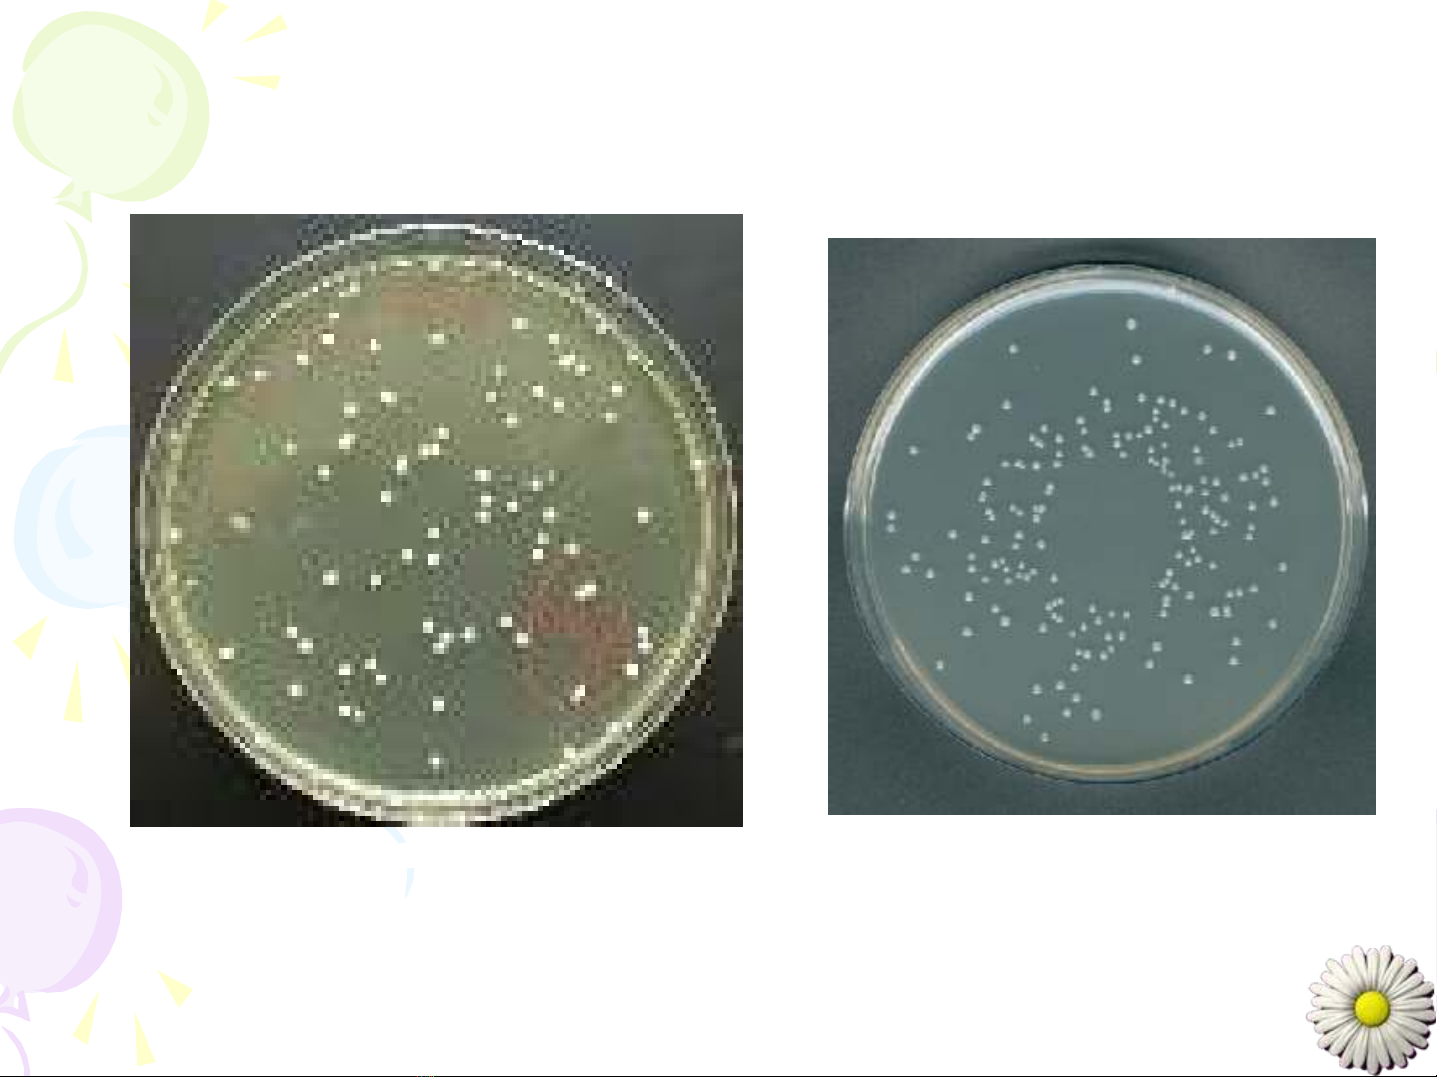

HÌNH THA
HÌNH THAÙÙI VA
I VAØØCA
CAÁÁU TA
U TAÏÏO TE
O TEÁÁBA
BAØØO
O
CA
CAÙÙC VI SINH VA
C VI SINH VAÄÄT NHAÂN NGUYEÂN THU
T NHAÂN NGUYEÂN THUÛÛY
Y
(PROKARYOTES)
(PROKARYOTES)
CHÖÔNG I:
I. Vi khuaån (Bacteria)
II. Xaï khuaån (Actinomycetes)
III. Vi khuaån lam (Cyanobacteria)
IV. Micoplatma (Mycoplasma)
V. Ricketxi (Ricketsia)
VI. Clamydia (Chlamydia)

I. VI KHUAÅN
1. Hình daïng - kích thöôùc
2. Caáu taïo teá baøo vi khuaån
3. Sinh saûn cuûa vi khuaån
4. Vai troø cuûa vi khuaån

1. Hình daïng vaø kích thöôùc
- Caùc daïng chuû yeáu:
HÌNH CAÀU HÌNH QUE
HÌNH PHAÅY HÌNH XOAÉN

So saùnh kích thöôùc vi khuaån vôùi ñaàu muõi kim
- Kích thöôùc: ÑK = 0,2 - 2μm, l = 2,0 – 8,0 μm